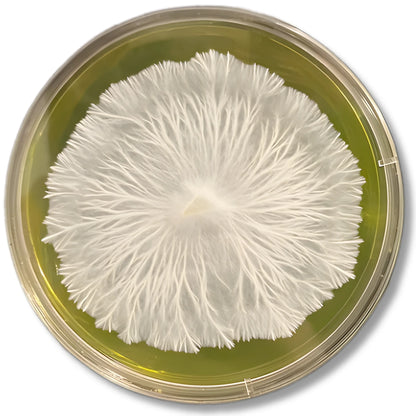
Placas de agar MYA pre-vertidas: medio de alta calidad para el cultivo de micelio con Parafilm gratis.
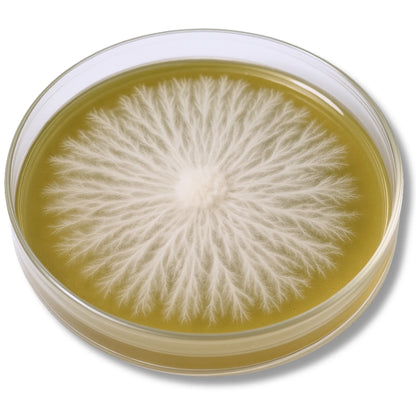
Placas de agar MYA pre-vertidas: medio de alta calidad para el cultivo de micelio con Parafilm gratis.

Optimiza tus proyectos de micología con placas de agar MYA pre-vertidas.
Simplifica la preparación de medios de cultivo con nuestras placas de agar MYA (malta y levadura) pre-vertidas . Especialmente formuladas para un crecimiento micelial robusto y rápido, estas placas son perfectas para el cultivo de hongos y otras aplicaciones microbiológicas. Diseñadas para ofrecer precisión y fiabilidad, son ideales tanto para profesionales como para aficionados.
Por qué te encantará:
✅ Listo para usar: Las placas de agar MYA pre-vertidas y esterilizadas le ahorran tiempo y esfuerzo, permitiéndole concentrarse en su cultivo o experimentos.
✅ Medio de cultivo rico en nutrientes: MYA está formulado específicamente para promover un desarrollo vigoroso del micelio y condiciones de crecimiento óptimas para diversos microorganismos.
✅ Parafilm gratuito incluido: Proteja sus muestras durante el almacenamiento o el transporte con el parafilm incluido.
✅ Múltiples opciones disponibles: Elija entre paquetes de 5, 10 o 20 placas para adaptarlas a las necesidades de su proyecto.
✅ Empaquetado para mayor comodidad: Las placas están empaquetadas de forma segura en película estéril, agrupadas en conjuntos de 5 para garantizar la limpieza y una manipulación libre de contaminación.
✅ Aplicaciones versátiles: Ideal para aislar, estudiar o propagar cultivos de hongos y otros microorganismos.
Alta calidad y estéril
Cada paquete de placas se prepara cuidadosamente para garantizar la esterilidad y la fiabilidad. Tanto si trabaja en un laboratorio profesional como si practica la micología como afición, estas placas le ofrecen una solución práctica y fiable para sus proyectos.
¡Pida hoy mismo sus placas de agar MYA pre-vertidas y mejore sus experimentos de micología o microbiología con facilidad y confianza!